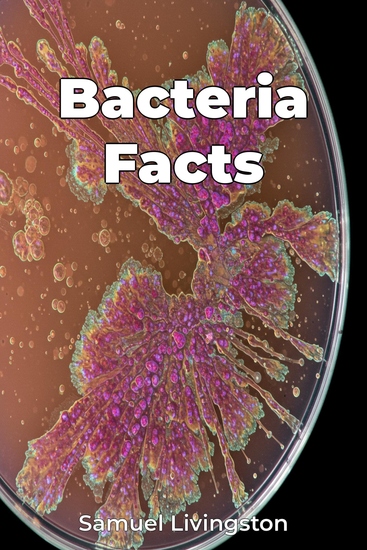

Bacteria Facts
Samuel Livingston
Tradutor A AI
Editora: Publifye
Sinopse
Bacteria Facts explores the microscopic world of bacteria, highlighting their essential role in life sciences and their impact on our planet. It investigates bacterial biology, ecological functions, and their influence on human health, revealing that bacteria are far more than just agents of disease. Did you know that the number of bacterial cells in your body exceeds the number of your own human cells? Or that bacteria drive critical biogeochemical cycles essential for life? This book presents a fact-based journey from the initial discovery of bacteria to modern advancements in microbiology. Beginning with the basics of bacterial structure and genetics, the narrative progresses to their diverse roles in ecosystems, from soil to the human microbiome. It culminates with an examination of both beneficial and pathogenic bacteria, addressing topics like antibiotic resistance and the potential of probiotics. Bacteria Facts offers a comprehensive yet accessible overview, connecting microbiology to fields like healthcare, environmental science, and biotechnology. It emphasizes the importance of understanding bacteria for advancing medicine, addressing environmental challenges, and developing new biotechnologies, making it valuable for students, healthcare professionals, and anyone curious about the microbial world.














